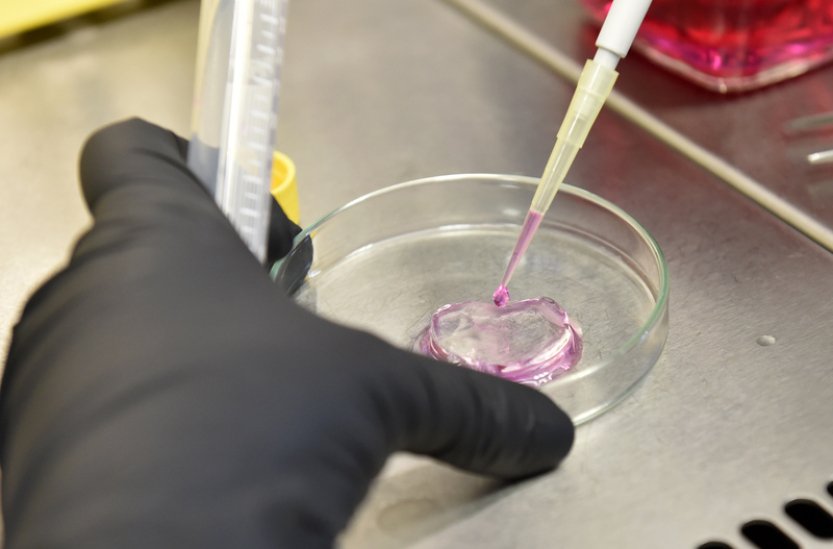
V mražených pelmeních v Písku byla salmonela, prodalo se jich téměř 500 kg

Při kontrole zásilky přijaté ze zahraničí ve skladu prodejce odebrala inspektorka vzorek z výše uvedeného výrobku a zaslala jej k vyšetření do Státního veterinárního ústavu Praha. To následně ukázalo přítomnost salmonel ve výrobku. Veterinární dozor zakázal pokračování v prodeji výrobku a nařídil jeho likvidaci v asanačním podniku na náklady prodejce, uvedl mluvčí. Pelmeně jsou plněné těstové taštičky masem, v těchto byla náplň z kuřecího masa. Prodával je obchod z řetězce Mere na Budějovickém Předměstí v Písku.
Salmonela se může do lidského těla dostat jak požitím kontaminované potraviny, tak z kontaminovaného prostředí, například z nádobí. Způsobuje onemocnění, které se většinou projevuje střevními problémy. Rizikové je pro seniory, nemocné lidi nebo malé děti. Bakterie lze zničit dostatečnou tepelnou úpravou potravin.